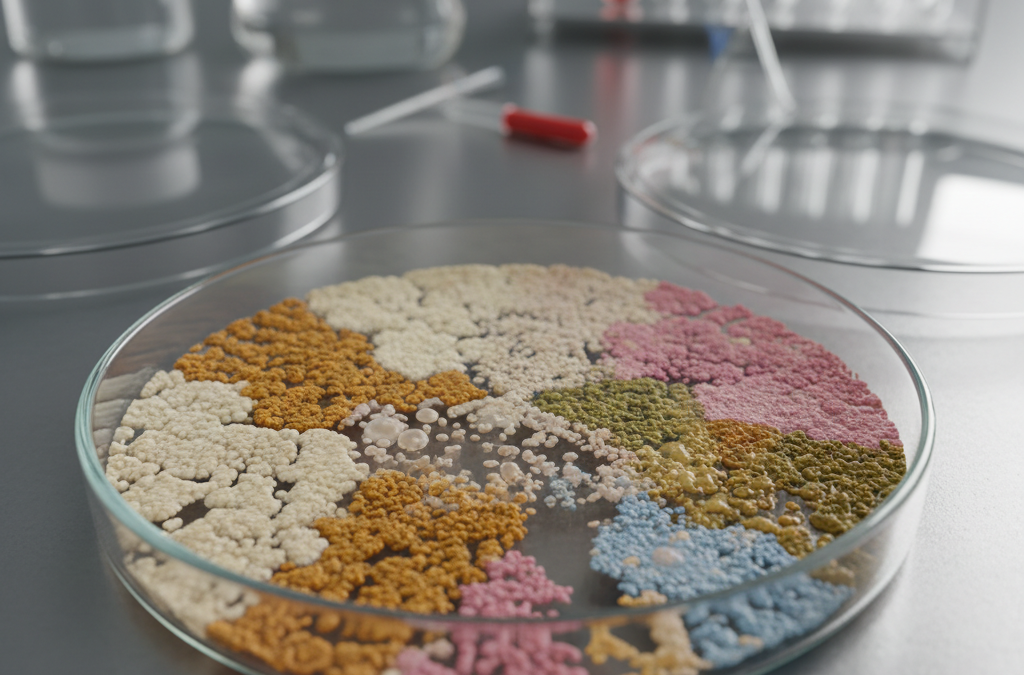

- Paraprobiotyki i postbiotyki to nieżywe komórki mikroorganizmów i ich metabolity, które modulują mikrobiotę jelitową w leczeniu otyłości.
- Działają bezpieczniej niż żywe probiotyki, nadając się nawet dla osób z obniżoną odpornością.
- Poprawiają stosunek Firmicutes/Bacteroidetes, zwiększają produkcję krótkołańcuchowych kwasów tłuszczowych, wzmacniają barierę jelitową i zmniejszają stan zapalny.
- Potrzebne są dalsze badania kliniczne na dużą skalę, by potwierdzić skuteczność i ustalić dawki.
Co to są paraprobiotyki i postbiotyki?
Paraprobiotyki to nieżywe komórki mikroorganizmów, natomiast postbiotyki obejmują metabolity oraz składniki strukturalne pochodzące z nieżyjących mikroorganizmów. Oba te związki różnią się od tradycyjnych żywych probiotyków, oferując bezpieczniejszy profil terapeutyczny. Mogą być stosowane nawet u osób z obniżoną odpornością, co czyni je obiecującą opcją w walce z otyłością.
Otyłość jako problem zdrowia publicznego
Otyłość stanowi poważny problem zdrowotny na całym świecie. Nowe strategie terapeutyczne skupiają się na modulacji mikrobioty jelitowej, która odgrywa kluczową rolę w metabolizmie organizmu. Paraprobiotyki i postbiotyki pojawiają się jako potencjalne uzupełnienie konwencjonalnych metod leczenia.
Mechanizmy działania w leczeniu otyłości
Te substancje korzystnie wpływają na otyłość poprzez równoważenie stosunku Firmicutes do Bacteroidetes w mikrobiocie jelitowej. Zwiększają produkcję krótkołańcuchowych kwasów tłuszczowych, wzmacniają integralność bariery jelitowej i redukują przewlekły stan zapalny. Badania przedkliniczne oraz ograniczone studia na ludziach wskazują na poprawę parametrów metabolicznych, masy tłuszczowej i masy ciała.
Szczególna rola wybranych szczepów
Zwłaszcza nieaktywowane formy pochodzące z Lactobacillus i Akkermansia wykazują pozytywne efekty. Te szczepy modulują mikrobiotę, prowadząc do korzystnych zmian w organizmie. Efekty te obserwowano w modelach przedklinicznych i wstępnych badaniach ludzkich.
Potrzeby dalszych badań
Paraprobiotyki i postbiotyki jawią się jako obiecujące uzupełnienie w zarządzaniu otyłością. Aby wprowadzić je do praktyki klinicznej, niezbędne są duże, randomizowane badania kontrolowane na ludziach. Kluczowe jest potwierdzenie skuteczności, określenie optymalnych dawek oraz zapewnienie stabilności formulacji.
Autorzy recenzji deklarują brak konfliktu interesów. Publikacja ukazała się w czasopiśmie Current Nutrition Reports w 2026 roku.
Źródło: Oryginalny artykuł

Komentarze czytelników 3
Bardzo fajny i merytoryczny tekst. Warto dodać, że kluczową rolę w tym procesie odgrywa nie tylko suplementacja, ale przede wszystkim odpowiednia podaż błonnika, który stanowi pożywkę dla naszych dobrych bakterii jelitowych. Ciekawostką jest to, że nawet jeśli przyjmujemy postbiotyki, bez odpowiedniej diety opartej na nieprzetworzonej żywności, efekty mogą być krótkotrwałe. Mikrobiota to niezwykle skomplikowany ekosystem, dlatego warto zadbać o różnorodność warzyw w codziennym jadłospisie, bo to one tworzą najlepsze warunki dla zdrowej flory bakteryjnej, która naturalnie wspiera metabolizm i pomaga utrzymać prawidłową masę ciała.
Jako osoba, która od lat zmaga się z problemami żołądkowymi i nadwagą, muszę przyznać, że po włączeniu suplementacji opartej na postbiotykach zauważyłem dużą różnicę. Nie schudłem co prawda w magiczny sposób bez diety, ale skończyły się moje ciągłe wzdęcia i uczucie ciężkości po każdym posiłku. Dzięki temu mam znacznie więcej energii do regularnych treningów, co przekłada się na wyniki na wadze. Warto jednak pamiętać, że to nie jest cudowna pigułka, a raczej wsparcie dla całego procesu zmiany stylu życia.
To brzmi niezwykle interesująco. Czy wiadomo już, w jakich produktach spożywczych najłatwiej znaleźć te paraprobiotyki i postbiotyki? Często czytam o żywych kulturach bakterii w jogurtach, ale nie mam pojęcia, czy te przetworzone formy, o których wspominacie w artykule, są już w ogóle dostępne w zwykłych sklepach. Chętnie spróbowałabym włączyć je do swojej diety, jeśli rzeczywiście mogą realnie pomóc w walce z opornymi kilogramami, ale nie wiem, od czego zacząć i jak czytać etykiety produktów pod tym kątem.
💬 Co sądzisz? Podziel się swoją opinią
Twój komentarz zostanie opublikowany po moderacji. Adres email nie będzie widoczny.